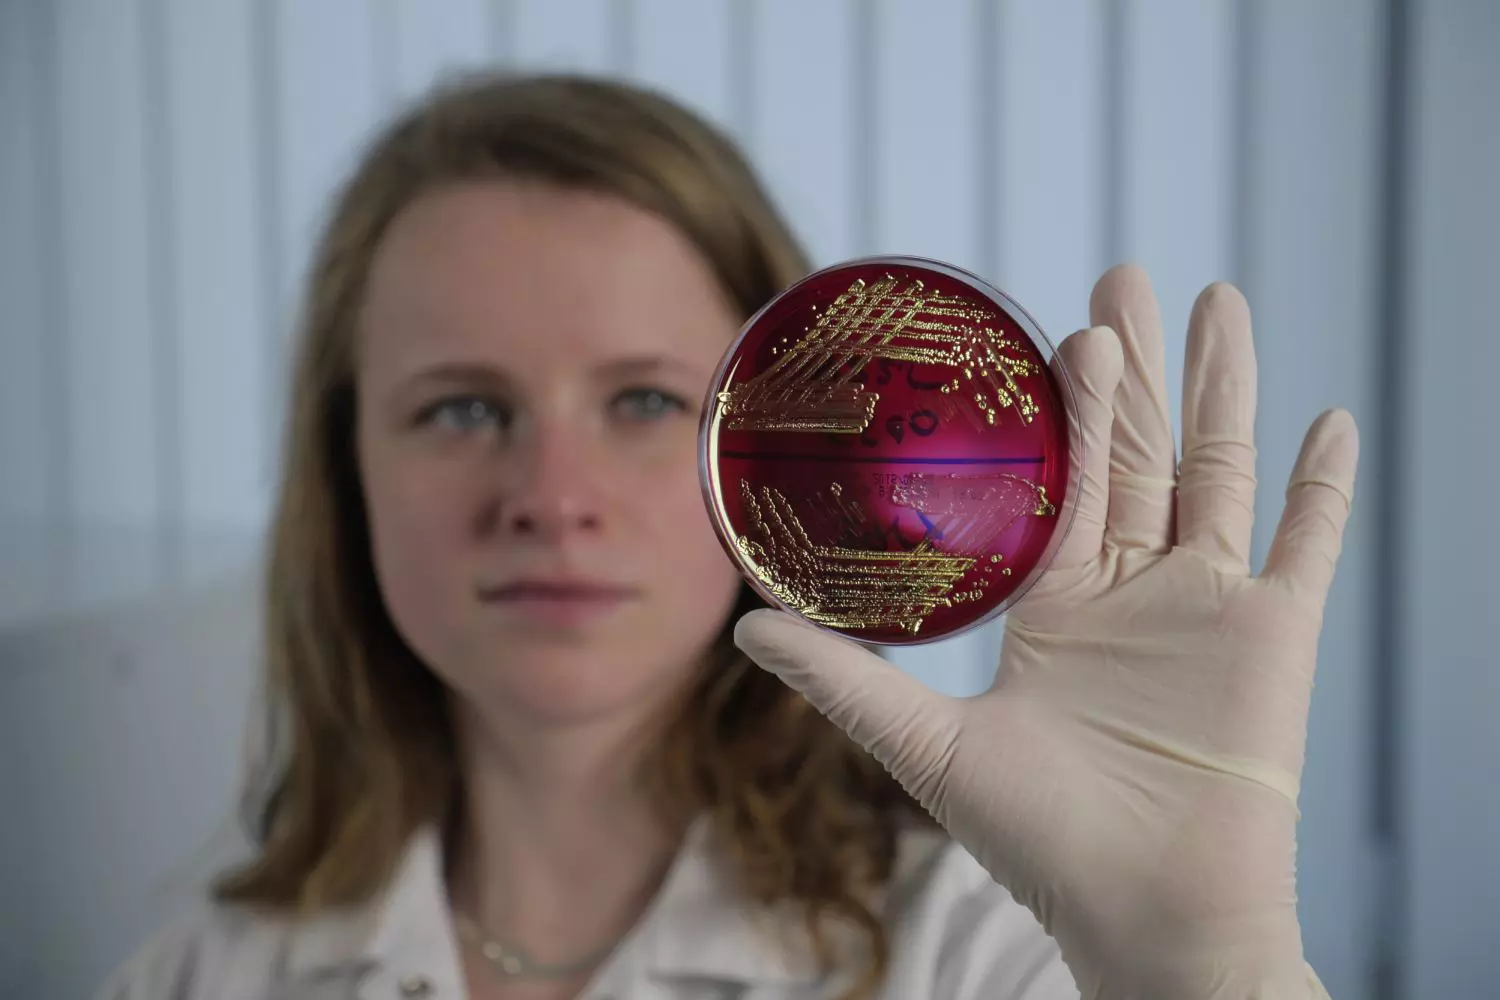

Český robotický systém pro přípravu vzorků pro analýzu zdroje infekce je nejlepší inovací v kategorii přístrojové techniky prezentovanou na prestižní konferenci se zaměřením na oblast analytické chemie a aplikované spektroskopie. Ocenění, které má ve zmiňovaných oblastech podobnou prestiž jako Red Dot ve světě designu, převzali zástupci firmy BioVendor Instruments na konferenci PITTCON 2017 v americkém Chicagu.
Rychlé a přesné určení zdroje infekce je pro správnou léčbu pacientů nezastupitelné. Moderní mikrobiologické laboratoře jsou vybaveny přístroji, které tyto nároky splňují, ale příprava vzorku k analýze je stále závislá na ruční práci laborantek a laborantů. Lidský faktor představuje největší potenciální riziko v celém léčebném procesu a pro přípravu a vyhodnocování vzorků v lékařské diagnostice, kde léčebný proces začíná, to platí dvojnásob.
MALDI COLONYST® je unikátní komerčně dostupný laboratorní robot, který umí automaticky přenášet mikrobiální kolonie z Petriho misky na MALDI destičku s terčíky a nanést činidlo. Robotické zařízení nepodléhá únavě a stresu, díky čemuž může podávat stabilní výkony prakticky neustále. Pomáhá tak redukovat lidskou chybu, zvyšuje přesnost identifikace původu infekce a tím předchází riziku chybné diagnózy a léčby pacientů.Jedná se o první zařízení svého typu na světě dostupné analytickým laboratořím.

robot MALDI Colonyst se zásobníkem Petriho misek a ocenění, které získal na prestižní konferenci Pittcon
„Ocenění dokazuje, že české společnosti orientované na vlastní výzkum a vývoj jsou schopné světových výsledků, které mohou předčit globální firmy existující na trhu nesrovnatelně delší dobu,“ říká Jan Karásek, výkonný ředitel firmy. Cesta k finálnímu produktu přitom nebyla jednoduchá.
Na vývoji zařízení se podílí i tým vědců z Biomedicínského centra Lékařské fakulty v Plzni Univerzity Karlovy pod vedením docenta Jaroslava Hrabáka a tým absolventů a studentů doktorského studia Vysokého učení technického v Brně, Fakulty informačních technologií a Fakulty elektrotechniky a komunikačních technologií, kteří se podíleli na vývoji kompletní mechaniky, elektroniky, řídicího systému a algoritmů pro zpracování a analýzu obrazu, které jsou nezbytné pro celkovou automatizaci procesu.
Ocenění MALDI COLONYST® je skvělým oceněním více než dvouleté spolupráce na vývoji zařízení mezi BioVendor Instruments a.s. a Univerzitou Karlovou. „Zařízení používáme k vlastnímu výzkumu a brzy se jej chystáme zavést i do rutinní klinické praxe,“ říká docent Jaroslav Hrabák z Univerzity Karlovy.
Petriho miska s mikrobiálními koloniemi připravená k dalšímu zpracování
Zdroj:
- Autor článku: ne
- Zdroj: JIC

